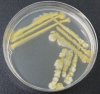
Kiemenabstrich.jpg
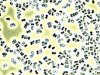
Micrococcus.jpg

Ein toter Koi mit einer Kiemennekrose und ein Kiemenabstrich, nicht mit einem Tupfer sondern direkt mit einer Öse auf einer PCA – Platte (Plate Count Agar) ausgeführt.
Der erfahrene Koihalter weiss bei diesem Bild sofort welcher Bösewicht hier am Werk war. Die dominante und gelbe Farbe des Bakterienwachstums lässt sofort auf Flavobakterien schliessen. Flavus oder Flavo bedeutet aus dem Lateinischen gelb.
Die Identifikation dieser gelbpigmentierten Bakterienkolonie bestätigte dann auch wirklich Flavobakterien.
Wenn es um Bakterien im Koiteich geht habe ich schon mehrmals bemerkt, sich nur der Erfassung der Gesamtkeimzahl zu widmen. Bei Verdacht von ungünstigem Bakterienbefall in den Kiemen, könnten jedoch mikrobiologisch interessierte und schon etwas geübte Koihalter durchaus mit einem sauberen Wattetupfer (wie Seite 42) eine entsprechende Probe fassen und auf einen PCA Dip Slide ausstreichen.
Nach zwei bis drei Tagen dunkel und bei Raumtemperatur (ohne Brutschrank) gelagert, kann das Wachstum interpretiert werden. Sollte auf dem Nährbodenträger ein dominierendes Gelb herrschen, würde ich mal den FishDoc anrufen.
Gelb bedeutet aber nicht zwangsläufig Flavobacteria. In der Wasserprobe eines Koiteiches sind auch andere Bakterien zu finden die sich gelb pigmentieren. Vor allem einige Pseudomonaden, Mikrokokken, ein Exot aus der Gattung Enterobacteria und sogar die lieben Laktobazillen können wenige Spezien vorweisen die sich gelb bekleiden lassen.
Der geübte „Mikroskopiker“ am Koiteich kann ab der gelben Bakterienkolonie, mit 800- oder besser 1‘000-facher Vergrösserung und mit Immersionsöl ausgerüstet, im Nativpräparat Flavobakterien von anderen Bakterien unterscheiden.
Folgend habe ich Mikrobilder der erwähnten Keime eingestellt.
Die Bakterienform Kokken zeigt sich Kugelförmig und lässt sich deutlich von den Stäbchen unterscheiden. Die Enterobakterien sind sehr kurze und abgerundete Stäbchen, Pseudomonaden sind deutlich länger als die Enterobakterien aber immer noch als kurze Stäbchen zu bezeichnen. Flavobakterien sind von den anderen beiden Stäbchen klar die längsten.
Ich schreibe nun nicht dass man dies tun soll aber mit mikrobiologischem Interesse und Übung wären solche Taten zu Hause und mit PCA Dip Slides durchaus möglich!
Gruss Dany